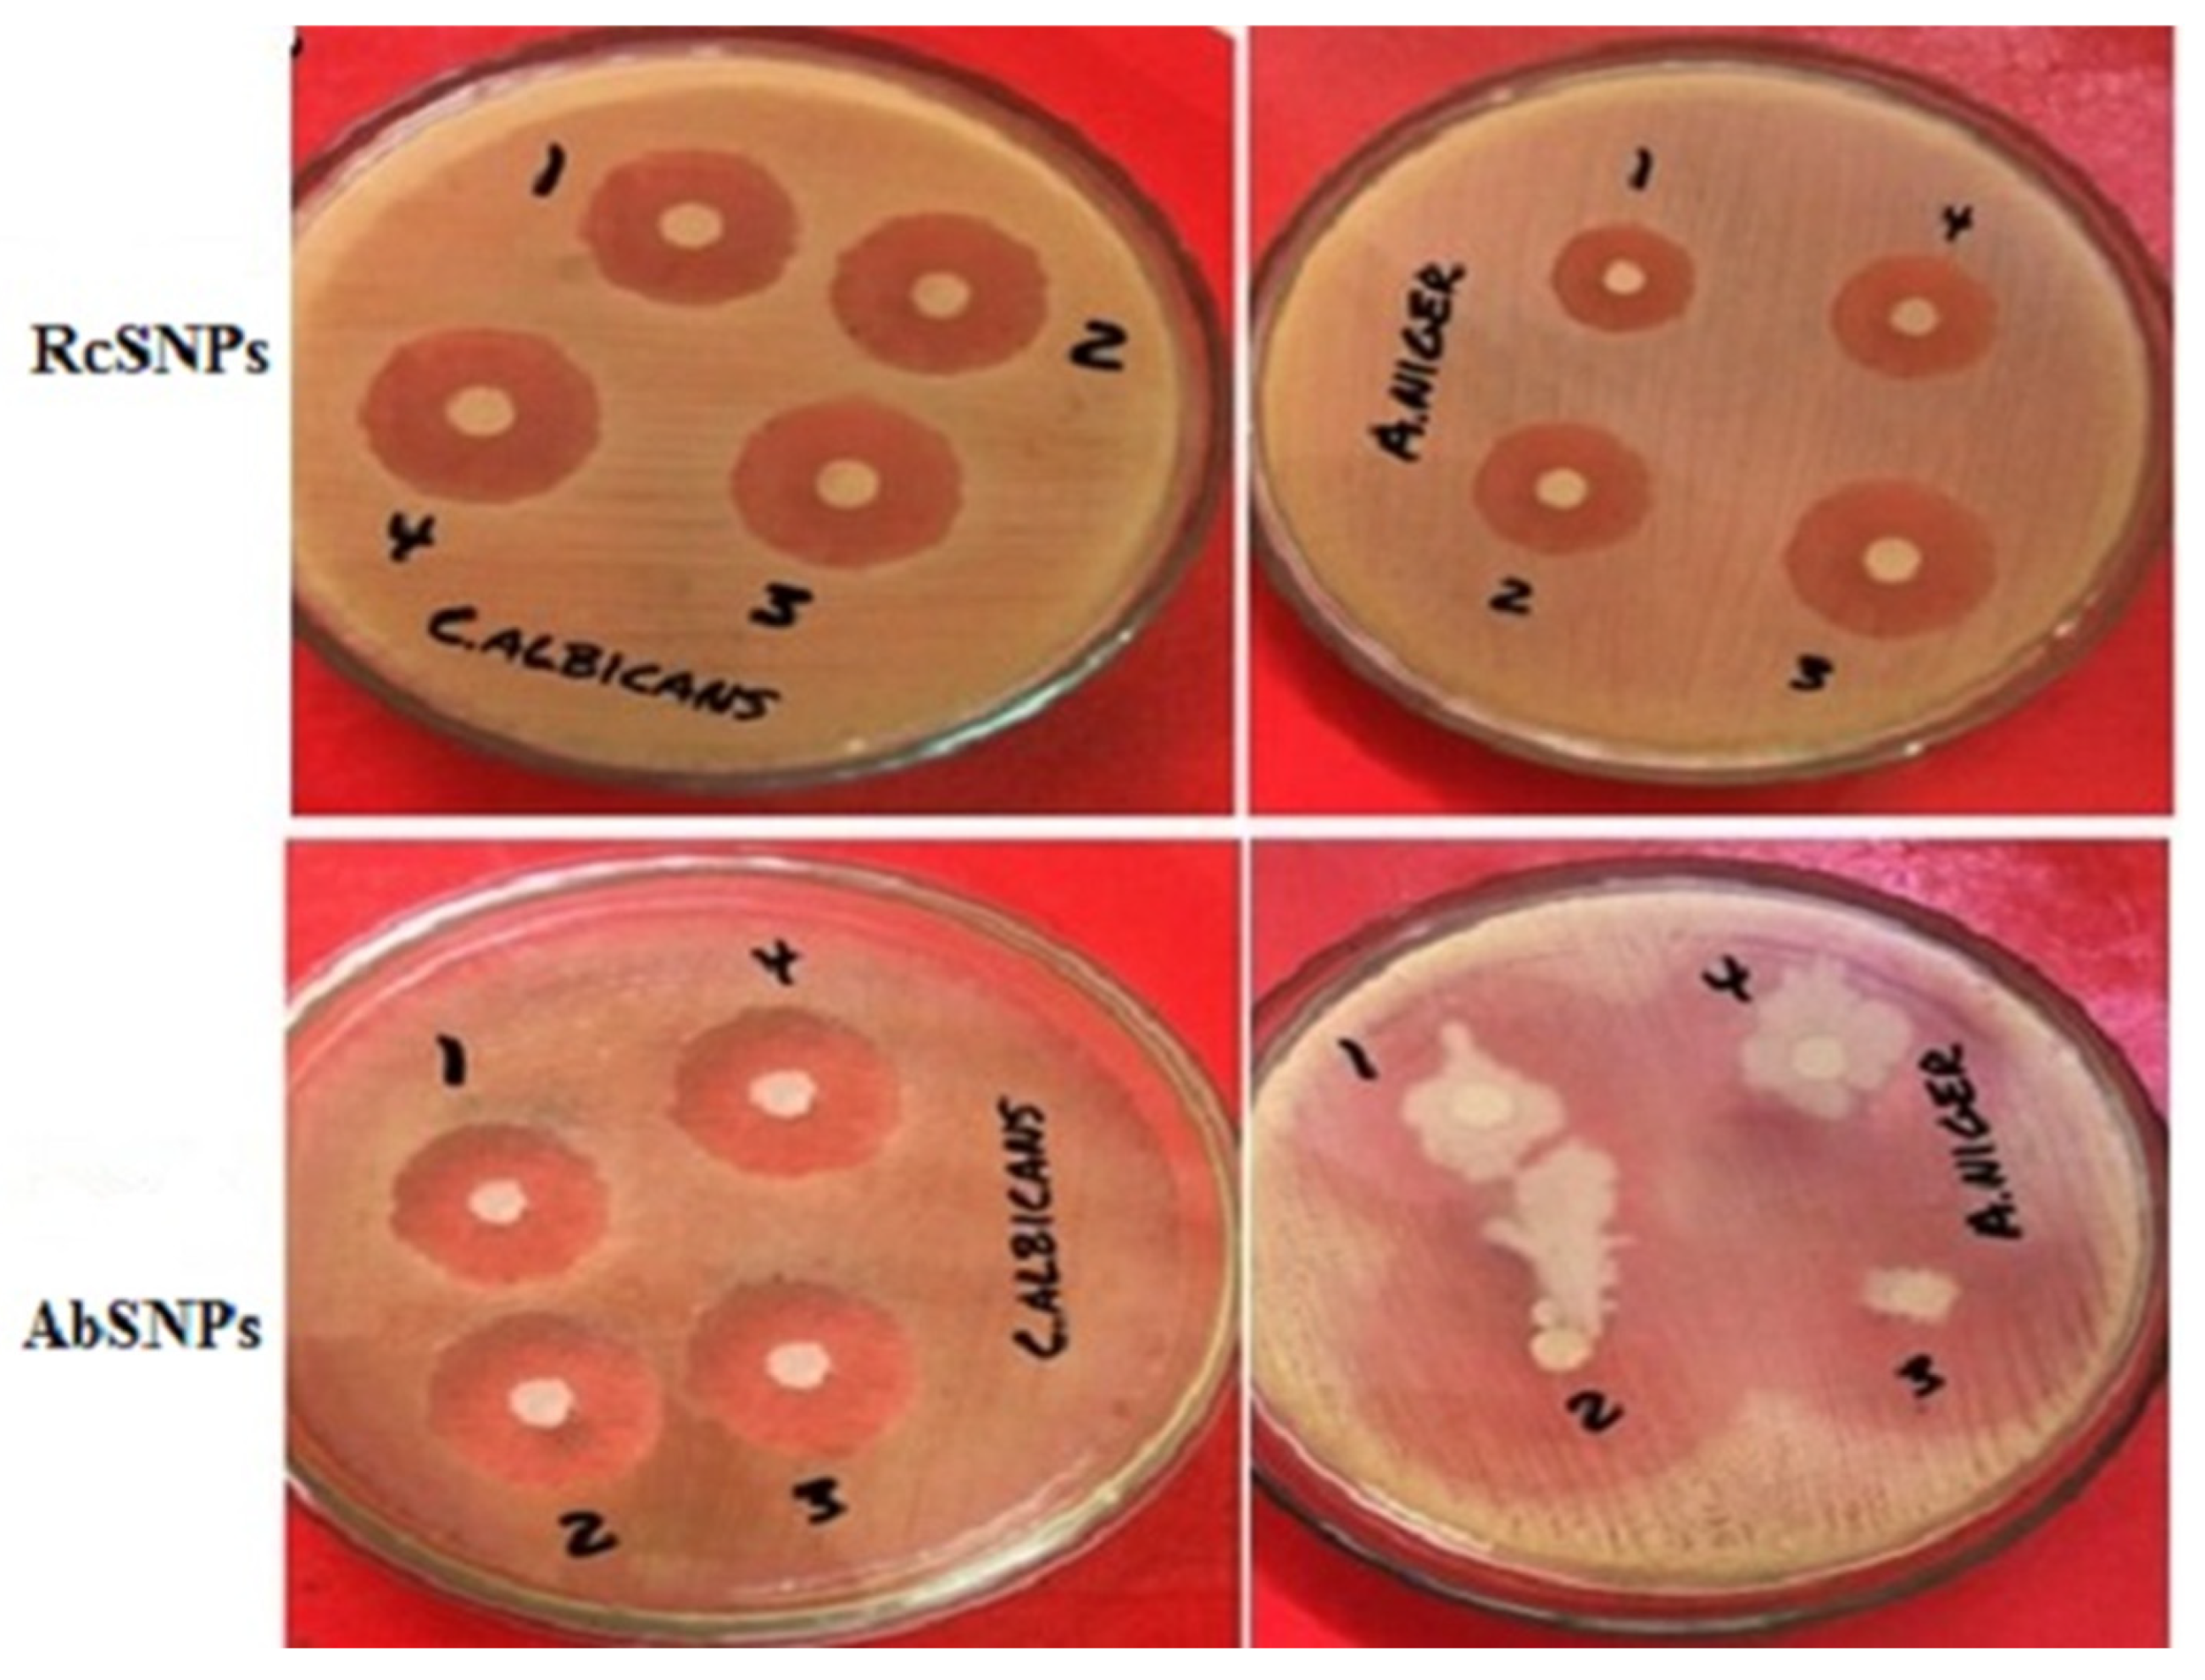
Bioengineering 12 01273 g010 Bioengineering 12 01273 g010

Phytogenic Silver Nanoparticles Derived from Ricinus communis and Aloe barbadensis: Synthesis, Characterization, and Evaluation of Biomedical Potential
Abstract
1. Introduction
2. Materials and Methods
2.1. Materials
2.2. Methods
2.2.1. Preparation of Plant Extracts
2.2.2. Phytochemical Analysis
2.2.3. Total Phenolic Content (TPC) Estimation
2.2.4. Biogenic Synthesis of Silver Nanoparticles (SNPs)
2.2.5. Optimization of SNP Synthesis
2.2.6. UV–Visible Spectroscopy
2.2.7. Stability Study
2.2.8. Characterization of SNPs
2.2.9. Antimicrobial Activity
2.2.10. In Vitro Anti-Inflammatory Assays
- Acontrol = absorbance of the control sample
- Asample = absorbance of the test sample
2.2.11. In Vitro Antioxidant Assays
2.2.12. Tyrosinase Inhibition
2.2.13. In Vitro Cytotoxicity
- ODsample = absorbance of treated cells
- ODcontrol = absorbance of untreated cells used as control.
2.2.14. Statistical Analysis
3. Results
3.1. Phytochemical Analysis
3.2. Visual Inspection
3.3. UV-Visible Spectroscopy
3.3.1. Effect of AgNO3 Concentration
3.3.2. Effect of Leaf Extract Concentration
3.3.3. Effect of Reaction Time
3.3.4. Effect of pH
3.3.5. Effect of Temperature
3.4. Stability of Synthesized SNPs
3.5. Dynamic Light Scattering (DLS) and Zeta Potential (ZP) Analysis
3.6. Fourier Transform Infrared (FTIR) Spectroscopy
3.7. Scanning Electron Microscopy (SEM) Analysis
3.8. Transmission Electron Microscopy (TEM) Analysis
3.9. Thermogravimetric Analysis (TGA) and Differential Scanning Calorimetry (DSC)
3.10. Antimicrobial Activity of Biogenic SNPs
3.11. In Vitro Anti-Inflammatory Assay
3.12. In Vitro Antioxidant Assay
3.13. Tyrosinase Inhibition Activity
3.14. In Vitro Cytotoxicity Evaluation
4. Discussion
4.1. Synthesis and Optimization of Silver Nanoparticles (SNPs)
4.2. Proposed Mechanism for RcSNPs and AbSNPs Synthesis
4.3. Characterization of SNPs
4.4. Therapeutic Evaluation of SNPs
5. Conclusions
Author Contributions
Funding
Informed Consent Statement
Data Availability Statement
Acknowledgments
Conflicts of Interest
References
- Hamida, R.S.; Abdelmeguid, N.E.; Ali, M.A.; Bin-Meferij, M.M.; Khalil, M.I. Synthesis of silver nanoparticles using a novel cyanobacteria Desertifilum sp. extract: Their antibacterial and cytotoxicity effects. Int. J. Nanomed. 2020, 15, 49–63. [Google Scholar] [CrossRef]
- Sriramulu, M.; Sumathi, S. Photocatalytic, antioxidant, antibacterial and anti-inflammatory activity of silver nanoparticles synthesised using forest and edible mushroom. Adv. Nat. Sci. Nanosci. Nanotechnol. 2017, 8, 045012. [Google Scholar] [CrossRef]
- Lateef, A.; Folarin, B.I.; Oladejo, S.M.; Akinola, P.O.; Beukes, L.S.; Gueguim-Kana, E.B. Characterization, antimicrobial, antioxidant, and anticoagulant activities of silver nanoparticles synthesized from Petiveria alliacea L. leaf extract. Prep. Biochem. Biotechnol. 2018, 48, 646–652. [Google Scholar] [CrossRef]
- Odeniyi, M.A.; Okumah, V.C.; Adebayo-Tayo, B.C.; Odeniyi, O.A. Green synthesis and cream formulations of silver nanoparticles of Nauclea latifolia (African peach) fruit extracts and evaluation of antimicrobial and antioxidant activities. Sustain. Chem. Pharm. 2020, 15, 100197. [Google Scholar] [CrossRef]
- Fatima, R.; Priya, M.; Indurthi, L.; Radhakrishnan, V.; Sudhakaran, R. Biosynthesis of silver nanoparticles using red algae Portieria hornemannii and its antibacterial activity against fish pathogens. Microb. Pathog. 2020, 138, 103780. [Google Scholar] [CrossRef]
- Wypij, M.; Czarnecka, J.; Świecimska, M.; Dahm, H.; Rai, M.; Golinska, P. Synthesis, characterization and evaluation of antimicrobial and cytotoxic activities of biogenic silver nanoparticles synthesized from Streptomyces xinghaiensis OF1 strain. World J. Microbiol. Biotechnol. 2018, 34, 23. [Google Scholar] [CrossRef]
- Govindappa, M.; Hemashekhar, B.; Arthikala, M.-K.; Rai, V.R.; Ramachandra, Y. Characterization, antibacterial, antioxidant, antidiabetic, anti-inflammatory and antityrosinase activity of green synthesized silver nanoparticles using Calophyllum tomentosum leaves extract. Results Phys. 2018, 9, 400–408. [Google Scholar] [CrossRef]
- Siddiquee, M.A.; ud din Parray, M.; Mehdi, S.H.; Alzahrani, K.A.; Alshehri, A.A.; Malik, M.A.; Patel, R. Green synthesis of silver nanoparticles from Delonix regia leaf extracts: In-vitro cytotoxicity and interaction studies with bovine serum albumin. Mater. Chem. Phys. 2020, 242, 122493. [Google Scholar] [CrossRef]
- Das, P.; Ghosal, K.; Jana, N.K.; Mukherjee, A.; Basak, P. Green synthesis and characterization of silver nanoparticles using belladonna mother tincture and its efficacy as a potential antibacterial and anti-inflammatory agent. Mater. Chem. Phys. 2019, 228, 310–317. [Google Scholar] [CrossRef]
- Ravichandran, V.; Vasanthi, S.; Shalini, S.; Shah, S.A.A.; Tripathy, M.; Paliwal, N. Green synthesis, characterization, antibacterial, antioxidant and photocatalytic activity of Parkia speciosa leaves extract mediated silver nanoparticles. Results Phys. 2019, 15, 102565. [Google Scholar] [CrossRef]
- Hamedi, S.; Shojaosadati, S.A. Rapid and green synthesis of silver nanoparticles using Diospyros lotus extract: Evaluation of their biological and catalytic activities. Polyhedron 2019, 171, 172–180. [Google Scholar] [CrossRef]
- Vanlalveni, C.; Lallianrawna, S.; Biswas, A.; Selvaraj, M.; Changmai, B.; Rokhum, S.L. Green synthesis of silver nanoparticles using plant extracts and their antimicrobial activities: A review of recent literature. RSC Adv. 2021, 11, 2804–2837. [Google Scholar] [CrossRef]
- Ahsan, A.; Farooq, M.A. Therapeutic potential of green synthesized silver nanoparticles loaded PVA hydrogel patches for wound healing. J. Drug Deliv. Sci. Technol. 2019, 54, 101308. [Google Scholar] [CrossRef]
- Shahzadi, S.; Fatima, S.; Shafiq, Z.; Janjua, M.R.S.A. A review on green synthesis of silver nanoparticles (SNPs) using plant extracts: A multifaceted approach in photocatalysis, environmental remediation, and biomedicine. RSC Adv. 2025, 15, 3858–3903. [Google Scholar] [CrossRef] [PubMed]
- Girón-Vázquez, N.; Gómez-Gutiérrez, C.; Soto-Robles, C.; Nava, O.; Lugo-Medina, E.; Castrejón-Sánchez, V.; Vilchis-Nestor, A.; Luque, P. Study of the effect of Persea americana seed in the green synthesis of silver nanoparticles and their antimicrobial properties. Results Phys. 2019, 13, 102142. [Google Scholar] [CrossRef]
- Thomas, B.; Vithiya, B.; Prasad, T.; Mohamed, S.; Magdalane, C.M.; Kaviyarasu, K.; Maaza, M. Antioxidant and photocatalytic activity of aqueous leaf extract mediated green synthesis of silver nanoparticles using Passiflora edulis f. flavicarpa. J. Nanosci. Nanotechnol. 2019, 19, 2640–2648. [Google Scholar] [CrossRef]
- Kumar, P.V.; Kalyani, R.; Veerla, S.C.; Kollu, P.; Shameem, U.; Pammi, S. Biogenic synthesis of stable silver nanoparticles via Asparagus racemosus root extract and their antibacterial efficacy towards human and fish bacterial pathogens. Mater. Res. Express 2019, 6, 104008. [Google Scholar] [CrossRef]
- Singh, P.; Ahn, S.; Kang, J.-P.; Veronika, S.; Huo, Y.; Singh, H.; Chokkaligam, M.; El-Agamy Farh, M.; Aceituno, V.C.; Kim, Y.J. In vitro anti-inflammatory activity of spherical silver nanoparticles and monodisperse hexagonal gold nanoparticles by fruit extract of Prunus serrulata: A green synthetic approach. Artif. Cells Nanomed. Biotechnol. 2018, 46, 2022–2032. [Google Scholar]
- Khosravi, A.; Zarepour, A.; Iravani, S.; Varma, R.S.; Zarrabi, A. Sustainable synthesis: Natural processes shaping the nanocircular economy. Environ. Sci. Nano 2024, 11, 688–707. [Google Scholar] [CrossRef]
- Zehra, S.H.; Ramzan, K.; Viskelis, J.; Viskelis, P.; Balciunaitiene, A. Advancements in Green Synthesis of Silver-Based Nanoparticles: Antimicrobial and Antifungal Properties in Various Films. Nanomaterials 2025, 15, 252. [Google Scholar] [CrossRef]
- Dhir, R.; Chauhan, S.; Subham, P.; Kumar, S.; Sharma, P.; Shidiki, A.; Kumar, G. Plant-mediated synthesis of silver nanoparticles: Unlocking their pharmacological potential–a comprehensive review. Front. Bioeng. Biotechnol. 2024, 11, 1324805. [Google Scholar] [CrossRef]
- Eker, F.; Akdaşçi, E.; Duman, H.; Bechelany, M.; Karav, S. Green synthesis of silver nanoparticles using plant extracts: A comprehensive review of physicochemical properties and multifunctional applications. Int. J. Mol. Sci. 2025, 26, 6222. [Google Scholar] [CrossRef]
- Ongtanasup, T.; Kamdenlek, P.; Manaspon, C.; Eawsakul, K. Green-synthesized silver nanoparticles from Zingiber officinale extract: Antioxidant potential, biocompatibility, anti-LOX properties, and in silico analysis. BMC Complement. Med. Ther. 2024, 24, 84. [Google Scholar] [CrossRef]
- Batra, N.; Dey, P. Untargeted metabolomics of Aloe volatiles: Implications in pathway enrichments for improved bioactivities. Heliyon 2025, 11, e42268. [Google Scholar] [CrossRef]
- Babu, A.T.; Antony, R. Green synthesis of silver doped nano metal oxides of zinc & copper for antibacterial properties, adsorption, catalytic hydrogenation & photodegradation of aromatics. J. Ind. Eng. Chem. 2019, 7, 102840. [Google Scholar]
- Khojasteh, D.; Kazerooni, M.; Salarian, S.; Kamali, R. Droplet impact on superhydrophobic surfaces: A review of recent developments. J. Ind. Eng. Chem. 2016, 42, 1–14. [Google Scholar] [CrossRef]
- Kumar, V.; Singh, D.K.; Mohan, S.; Gundampati, R.K.; Hasan, S.H. Photoinduced green synthesis of silver nanoparticles using aqueous extract of Physalis angulata and its antibacterial and antioxidant activity. J. Environ. Chem. Eng. 2017, 5, 744–756. [Google Scholar] [CrossRef]
- Salih, H.; Altameemi, R.; Al-Azawi, A. Antibacterial activity of silver nanoparticles prepared from Camellia sinensis extracts in multi-drug resistant Staphylococcus Aureus. Cell Physiol. Biochem. 2024, 58, 659–676. [Google Scholar]
- Sowmyya, T. Spectroscopic investigation on catalytic and bactericidal properties of biogenic silver nanoparticles synthesized using Soymida febrifuga aqueous stem bark extract. J. Environ. Chem. Eng. 2018, 6, 3590–3601. [Google Scholar] [CrossRef]
- Vickers, N.J. Animal communication: When i’m calling you, will you answer too? Curr. Biol. 2017, 27, R713–R715. [Google Scholar] [CrossRef]
- Khatun, M.; Khatun, Z.; Karim, M.R.; Habib, M.R.; Rahman, M.H.; Aziz, M.A. Green synthesis of silver nanoparticles using extracts of Mikania cordata leaves and evaluation of their antioxidant, antimicrobial and cytotoxic properties. Food Chem. Adv. 2023, 3, 100386. [Google Scholar] [CrossRef]
- Parlinska-Wojtan, M.; Kus-Liskiewicz, M.; Depciuch, J.; Sadik, O. Green synthesis and antibacterial effects of aqueous colloidal solutions of silver nanoparticles using camomile terpenoids as a combined reducing and capping agent. Bioprocess Biosyst. Eng. 2016, 39, 1213–1223. [Google Scholar] [CrossRef]
- Melo, P.S.; Massarioli, A.P.; Denny, C.; dos Santos, L.F.; Franchin, M.; Pereira, G.E.; de Souza Vieira, T.M.F.; Rosalen, P.L.; de Alencar, S.M. Winery by-products: Extraction optimization, phenolic composition and cytotoxic evaluation to act as a new source of scavenging of reactive oxygen species. Food Chem. 2015, 181, 160–169. [Google Scholar] [CrossRef]
- Raota, C.S.; Cerbaro, A.F.; Salvador, M.; Delamare, A.P.L.; Echeverrigaray, S.; da Silva Crespo, J.; da Silva, T.B.; Giovanela, M. Green synthesis of silver nanoparticles using an extract of Ives cultivar (Vitis labrusca) pomace: Characterization and application in wastewater disinfection. J. Environ. Chem. Eng. 2019, 7, 103383. [Google Scholar] [CrossRef]
- Behravan, M.; Panahi, A.H.; Naghizadeh, A.; Ziaee, M.; Mahdavi, R.; Mirzapour, A. Facile green synthesis of silver nanoparticles using Berberis vulgaris leaf and root aqueous extract and its antibacterial activity. Int. J. Biol. Macromol. 2019, 124, 148–154. [Google Scholar] [CrossRef]
- Azad, A.; Zafar, H.; Raza, F.; Sulaiman, M. Factors influencing the green synthesis of metallic nanoparticles using plant extracts: A comprehensive review. Pharm. Fronts 2023, 5, e117–e131. [Google Scholar] [CrossRef]
- Bhatnagar, S.; Aoyagi, H. Current overview of the mechanistic pathways and influence of physicochemical parameters on the microbial synthesis and applications of metallic nanoparticles. Bioprocess Biosyst. Eng. 2025, 48, 1779–1800. [Google Scholar] [CrossRef]
- Abomughaid, M.M.; Teibo, J.O.; Akinfe, O.A.; Adewolu, A.M.; Teibo, T.K.A.; Afifi, M.; Al-Farga, A.M.H.; Al-kuraishy, H.M.; Al-Gareeb, A.I.; Alexiou, A. A phytochemical and pharmacological review of Ricinus communis L. Discov. Appl. Sci. 2024, 6, 315. [Google Scholar]
- Matei, C.E.; Visan, A.I.; Cristescu, R. Aloe Vera Polysaccharides as Therapeutic Agents: Benefits Versus Side Effects in Biomedical Applications. Polysaccharides 2025, 6, 36. [Google Scholar] [CrossRef]
- Ramothloa, T.P.; Mkolo, N.M.; Motshudi, M.C.; Mphephu, M.M.; Makhafola, M.A.; Naidoo, C.M. Phytochemical Composition and Multifunctional Applications of Ricinus communis L.: Insights into Therapeutic, Pharmacological, and Industrial Potential. Molecules 2025, 30, 3214. [Google Scholar] [CrossRef]
- Rahmati, S.; Tavallali, V.; Jahromi, M.H.G. Comparison of pectin and Aloe vera extract in green synthesis and enhanced stability and antioxidant activity of calcium nanostructure. Appl. Organomet. Chem. 2025, 39, e70077. [Google Scholar] [CrossRef]
- Osman, A.I.; Zhang, Y.; Farghali, M.; Rashwan, A.K.; Eltaweil, A.S.; Abd El-Monaem, E.M.; Mohamed, I.M.; Badr, M.M.; Ihara, I.; Rooney, D.W. Synthesis of green nanoparticles for energy, biomedical, environmental, agricultural, and food applications: A review. Environ. Chem. Lett. 2024, 22, 841–887. [Google Scholar] [CrossRef]
- Sharma, N.K.; Vishwakarma, J.; Rai, S.; Alomar, T.S.; AlMasoud, N.; Bhattarai, A. Green route synthesis and characterization techniques of silver nanoparticles and their biological adeptness. ACS Omega 2022, 7, 27004–27020. [Google Scholar] [CrossRef]
- Trease, G.E.; Evans, W.C. Pharmacognosy, 12th ed.; Tindall & Co.: London, UK, 1983. [Google Scholar]
- Harborne, A. Phytochemical Methods a Guide to Modern Techniques of Plant Analysis; Springer Science & Business Media: Berlin, Germany, 1998. [Google Scholar]
- Sofowora, A. Research on medicinal plants and traditional medicine in Africa. J. Altern. Complement. Med. 1996, 2, 365–372. [Google Scholar] [CrossRef] [PubMed]
- Singh, R.; Singh, R.; Parihar, P.; Mani, J.V. Green synthesis of silver nanoparticles using Solanum sisymbriifolium leaf extract: Characterization and evaluation of antioxidant, antibacterial and photocatalytic degradation activities. Process Biochem. 2024, 143, 337–352. [Google Scholar] [CrossRef]
- Evans, W.C. Trease and Evans’ pharmacognosy. Gen. Pharmacol. 1997, 2, 291. [Google Scholar]
- Urquiaga, I.; Leighton, F. Plant polyphenol antioxidants and oxidative stress. Biol. Res. 2000, 33, 55–64. [Google Scholar] [CrossRef] [PubMed]
- Obadoni, B.; Ochuko, P. Phytochemical studies and comparative efficacy of the crude extracts of some haemostatic plants in Edo and Delta States of Nigeria. Glob. J. Pure Appl. Sci. 2002, 8, 203–208. [Google Scholar] [CrossRef]
- Al-Dhabi, N.A.; Ponmurugan, K.; Jeganathan, P.M. Development and validation of ultrasound-assisted solid-liquid extraction of phenolic compounds from waste spent coffee grounds. Ultrason. Sonochem. 2017, 34, 206–213. [Google Scholar] [CrossRef]
- Ojo, O.A.; Oyinloye, B.E.; Ojo, A.B.; Afolabi, O.B.; Peters, O.A.; Olaiya, O.; Fadaka, A.; Jonathan, J.; Osunlana, O. Green synthesis of silver nanoparticles (AgNPs) using Talinum triangulare (Jacq.) Willd. leaf extract and monitoring their antimicrobial activity. J. Bionanosci. 2017, 11, 292–296. [Google Scholar] [CrossRef]
- Kumar, B.; Smita, K.; Cumbal, L.; Debut, A. Green synthesis of silver nanoparticles using Andean blackberry fruit extract. Saudi J. Biol. Sci. 2017, 24, 45–50. [Google Scholar] [CrossRef]
- Alam, A.; Tanveer, F.; Khalil, A.T.; Zohra, T.; Khamlich, S.; Alam, M.M.; Salman, M.; Ali, M.; Ikram, A.; Shinwari, Z.K. Silver nanoparticles biosynthesized from secondary metabolite producing marine actinobacteria and evaluation of their biomedical potential. Antonie Van Leeuwenhoek 2021, 114, 1497–1516. [Google Scholar] [CrossRef]
- Yildirim, K.; Atas, C.; Simsek, E.; Coban, A.Y. The effect of inoculum size on antimicrobial susceptibility testing of Mycobacterium tuberculosis. Microbiol. Spectr. 2023, 11, e00319-23. [Google Scholar] [CrossRef]
- Behera, M.; Soren, S.; Singh, N.R.; Sipra, B.; Sethi, G.; Mahanandia, S.; Pradhan, B.; Bhanjadeo, M. Green Synthesis of Bovine Serum Albumin Conjugated Silver Nanoparticles at Different Temperatures and Evaluation of Their Antioxidant Activity. Indian J. Pharm. Sci. 2024, 86, 1690–1701. [Google Scholar] [CrossRef]
- Banik, S.; Biswas, S.; Karmakar, S. Extraction, purification, and activity of protease from the leaves of Moringa oleifera. F1000Research 2018, 7, 1151. [Google Scholar] [CrossRef] [PubMed]
- Prem, P.; Naveenkumar, S.; Kamaraj, C.; Ragavendran, C.; Priyadharsan, A.; Manimaran, K.; Alharbi, N.S.; Rarokar, N.; Cherian, T.; Sugumar, V. Valeriana jatamansi root extract a potent source for biosynthesis of silver nanoparticles and their biomedical applications, and photocatalytic decomposition. Green Chem. Lett. Rev. 2024, 17, 2305142. [Google Scholar] [CrossRef]
- Madeshwaran, K.; Venkatachalam, R. Green synthesis of bimetallic ZnO–CuO nanoparticles using Annona muricata l. extract: Investigation of antimicrobial, antioxidant, and anticancer properties. J. Ind. Eng. Chem. 2024, 140, 454–467. [Google Scholar] [CrossRef]
- Pathak, P.; Shukla, P.; Kanshana, J.S.; Jagavelu, K.; Sangwan, N.S.; Dwivedi, A.K.; Dikshit, M. Standardized root extract of Withania somnifera and Withanolide A exert moderate vasorelaxant effect in the rat aortic rings by enhancing nitric oxide generation. J. Ethnopharmacol. 2021, 278, 114296. [Google Scholar] [CrossRef]
- Alemu, B.; Molla, M.D.; Tezera, H.; Dekebo, A.; Asmamaw, T. Phytochemical composition and in vitro antioxidant and antimicrobial activities of Bersama abyssinica F. seed extracts. Sci. Rep. 2024, 14, 6345. [Google Scholar] [CrossRef]
- Chandrasekhar, N.; Vinay, S. Yellow colored blooms of Argemone mexicana and Turnera ulmifolia mediated synthesis of silver nanoparticles and study of their antibacterial and antioxidant activity. Appl. Nanosci. 2017, 7, 851–861. [Google Scholar] [CrossRef]
- Giridasappa, A.; Ismail, S.M.; Gopinath, S. Antioxidant, Bactericidal, Antihemolytic, and Anticancer Assessment Activities of Al2O3, SnO2, and Green Synthesized Ag and CuO NPs. In Handbook of Sustainable Materials: Modelling, Characterization, and Optimization; CRC Press: Boca Raton, FL, USA, 2023; pp. 367–398. [Google Scholar]
- Mughal, S.S. Role of silver nanoparticles in colorimetric detection of biomolecules. Authorea 2022. Preprint. [Google Scholar] [CrossRef]
- Singh, P.; Mijakovic, I. Green synthesis and antibacterial applications of gold and silver nanoparticles from Ligustrum vulgare berries. Sci. Rep. 2022, 12, 7902. [Google Scholar] [CrossRef] [PubMed]
- Tavan, M.; Hanachi, P.; Mirjalili, M.H.; Dashtbani-Roozbehani, A. Comparative assessment of the biological activity of the green synthesized silver nanoparticles and aqueous leaf extract of Perilla frutescens (L.). Sci. Rep. 2023, 13, 6391. [Google Scholar] [CrossRef] [PubMed]
- Alim-Al-Razy, M.; Bayazid, G.A.; Rahman, R.U.; Bosu, R.; Shamma, S.S. Silver nanoparticle synthesis, UV-Vis spectroscopy to find particle size and measure resistance of colloidal solution. J. Phys. Conf. Ser. 2020, 1706, 12020. [Google Scholar] [CrossRef]
- Pasieczna-Patkowska, S.; Cichy, M.; Flieger, J. Application of Fourier transform infrared (FTIR) spectroscopy in characterization of green synthesized nanoparticles. Molecules 2025, 30, 684. [Google Scholar] [CrossRef]
- Gao, C.; Lu, Z.; Liu, Y.; Zhang, Q.; Chi, M.; Cheng, Q.; Yin, Y. Highly stable silver nanoplates for surface plasmon resonance biosensing. Angew. Chem. Int. Ed. 2012, 51, 5629–5633. [Google Scholar] [CrossRef]
- Jia, Z.; Li, J.; Gao, L.; Yang, D.; Kanaev, A. Dynamic light scattering: A powerful tool for in situ nanoparticle sizing. Colloids Interfaces 2023, 7, 15. [Google Scholar] [CrossRef]
- Sun, Q.; Cai, X.; Li, J.; Zheng, M.; Chen, Z.; Yu, C.-P. Green synthesis of silver nanoparticles using tea leaf extract and evaluation of their stability and antibacterial activity. Colloids Surf. A Physicochem. Eng. Asp. 2014, 444, 226–231. [Google Scholar] [CrossRef]
- Sreelekha, E.; George, B.; Shyam, A.; Sajina, N.; Mathew, B. A comparative study on the synthesis, characterization, and antioxidant activity of green and chemically synthesized silver nanoparticles. J. Bionanosci. 2021, 11, 489–496. [Google Scholar] [CrossRef]
- Kumaran, N.S. In vitro anti-inflammatory activity of silver nanoparticle synthesized Avicennia marina (Forssk.) Vierh.: A green synthetic approach. Int. J. Green Pharm. 2018, 12, S528–S536. [Google Scholar]
- Yakop, F.; Abd Ghafar, S.A.; Yong, Y.K.; Saiful Yazan, L.; Mohamad Hanafiah, R.; Lim, V.; Eshak, Z. Silver nanoparticles Clinacanthus Nutans leaves extract induced apoptosis towards oral squamous cell carcinoma cell lines. Artif. Cells Nanomed. Biotechnol. 2018, 46, 131–139. [Google Scholar] [CrossRef]
- Nasrollahzadeh, M.; Issaabadi, Z.; Sajadi, S.M. Green synthesis of the Ag/Al2O3 nanoparticles using Bryonia alba leaf extract and their catalytic application for the degradation of organic pollutants. J. Mater. Sci. Mater. Electron. 2019, 30, 3847–3859. [Google Scholar] [CrossRef]
- Deshpande, B.; Sharma, D.; Pandey, B. Phytochemicals and antibacterial screening of Parthenium hysterophorus. Indian J. Sci. Res. 2017, 13, 199–202. [Google Scholar]
- Khan, T.; Ullah, N.; Khan, M.A.; Mashwani, Z.u.R.; Nadhman, A. Plant-based gold nanoparticles; a comprehensive review of the decade-long research on synthesis, mechanistic aspects and diverse applications. Adv. Colloid Interface Sci. 2019, 272, 102017. [Google Scholar] [CrossRef]
- Singh, R. Chemotaxonomy of medicinal plants: Possibilities and limitations. In Natural Products and Drug Discovery; Elsevier: Amsterdam, The Netherlands, 2018; pp. 119–136. [Google Scholar]
- Dharajiya, D.; Pagi, N.; Jasani, H.; Patel, P. Antimicrobial activity and phytochemical screening of Aloe vera (Aloe barbadensis Miller). Int. J. Curr. Microbiol. App. Sci. 2017, 6, 2152–2162. [Google Scholar]
- Baba, S.A.; Malik, S.A. Determination of total phenolic and flavonoid content, antimicrobial and antioxidant activity of a root extract of Arisaema jacquemontii Blume. J. Taibah Univ. Sci. 2015, 9, 449–454. [Google Scholar] [CrossRef]
- Chen, Z.; Świsłocka, R.; Choińska, R.; Marszałek, K.; Dąbrowska, A.; Lewandowski, W.; Lewandowska, H. Exploring the correlation between the molecular structure and biological activities of metal–phenolic compound complexes: Research and description of the role of metal ions in improving the antioxidant activities of phenolic compounds. Int. J. Mol. Sci. 2024, 25, 11775. [Google Scholar] [CrossRef]
- Dakshayani, S.; Marulasiddeshwara, M.; Sharath Kumar, M.; Raghavendra Kumar, P.; Devaraja, S. Antimicrobial, anticoagulant and antiplatelet activities of green synthesized silver nanoparticles using Selaginella (Sanjeevini) plant extract. Int. J. Biol. Macromol. 2019, 131, 787–797. [Google Scholar] [CrossRef] [PubMed]
- Song, X.-C.; Canellas, E.; Asensio, E.; Nerín, C. Predicting the antioxidant capacity and total phenolic content of bearberry leaves by data fusion of UV–Vis spectroscopy and UHPLC/Q-TOF-MS. Talanta 2020, 213, 120831. [Google Scholar] [CrossRef] [PubMed]
- Lama-Muñoz, A.; del Mar Contreras, M.; Espínola, F.; Moya, M.; Romero, I.; Castro, E. Content of phenolic compounds and mannitol in olive leaves extracts from six Spanish cultivars: Extraction with the Soxhlet method and pressurized liquids. Food Chem. 2020, 320, 126626. [Google Scholar] [CrossRef]
- Ahmed-Gaid, K.; Ahmed-Gaid, N.E.Y.; Hanoun, S.; Chenna, H.; Ghenaiet, K.; Ahmed-Gaid, H.; Hadef, Y. Phenolic compounds, antioxidant, and antimicrobial activities of methanolic extract from the saharan endemic plant haloxylon scoparium pomel. Bull. Pharm. Sci. Assiut Univ. 2025, 48, 267–276. [Google Scholar] [CrossRef]
- Marius, L.; Kini, F.; Pierre, D.; Pierre, G.I. In vitro antioxidant activity and phenolic contents of different fractions of ethanolic extract from Khaya senegalensis A. Juss. (Meliaceae) stem barks. Afr. J. Pharm. Pharmacol. 2016, 10, 501–507. [Google Scholar] [CrossRef]
- Khawory, M.H.; Amanah, A.; Salin, N.H.; Mohd Subki, M.F.; Mohd Nasim, N.N.; Noordin, M.I.; Wahab, H.A. Effects of Gamma Radiation Treatment on Medicinal Plants for Both Qualitative and Quantitative Analysis of Phenolic Acid. Available online: https://ssrn.com/abstract=4334860 (accessed on 25 January 2023).
- Veerasamy, R.; Xin, T.Z.; Gunasagaran, S.; Xiang, T.F.W.; Yang, E.F.C.; Jeyakumar, N.; Dhanaraj, S.A. Biosynthesis of silver nanoparticles using mangosteen leaf extract and evaluation of their antimicrobial activities. J. Saudi Chem. Soc. 2011, 15, 113–120. [Google Scholar] [CrossRef]
- Banerjee, P.; Satapathy, M.; Mukhopahayay, A.; Das, P. Leaf extract mediated green synthesis of silver nanoparticles from widely available Indian plants: Synthesis, characterization, antimicrobial property and toxicity analysis. Bioresour. Bioprocess. 2014, 1, 3. [Google Scholar] [CrossRef]
- Chandran, N.; Bayal, M.; Pilankatta, R.; Nair, S.S. Tuning of surface Plasmon resonance (SPR) in metallic nanoparticles for their applications in SERS. In Nanomaterials for Luminescent Devices, Sensors, and Bio-Imaging Applications; Springer: Berlin/Heidelberg, Germany, 2021; pp. 39–66. [Google Scholar]
- Yadav, M.; Gaur, N.; Wahi, N.; Singh, S.; Kumar, K.; Amoozegar, A.; Sharma, E. Phytochemical-Assisted Fabrication of Biogenic Silver Nanoparticles from Vitex negundo: Structural Features, Antibacterial Activity, and Cytotoxicity Evaluation. Colloids Interfaces 2025, 9, 55. [Google Scholar] [CrossRef]
- Kale, G.; Bhatkar, D.; Rokade, S.; Ingle, P.; Patil, R. Green synthesis of silver nanoparticles using Azadirachta indica leaves extract and characterization by UV. Sustain. Dev. 2022, 1695, 1695–1699. [Google Scholar]
- Markus, J.; Wang, D.; Kim, Y.-J.; Ahn, S.; Mathiyalagan, R.; Wang, C.; Yang, D.C. Biosynthesis, characterization, and bioactivities evaluation of silver and gold nanoparticles mediated by the roots of Chinese herbal Angelica pubescens Maxim. Nanoscale Res. Lett. 2017, 12, 46. [Google Scholar] [CrossRef] [PubMed]
- Kaabipour, S.; Hemmati, S. A review on the green and sustainable synthesis of silver nanoparticles and one-dimensional silver nanostructures. Beilstein J. Nanotechnol. 2021, 12, 102–136. [Google Scholar] [CrossRef]
- Chirumamilla, P.; Dharavath, S.B.; Taduri, S. Eco-friendly green synthesis of silver nanoparticles from leaf extract of Solanum khasianum: Optical properties and biological applications. Appl. Biochem. Biotechnol. 2023, 195, 353–368. [Google Scholar] [CrossRef] [PubMed]
- Sinha, S.N.; Paul, D.; Halder, N.; Sengupta, D.; Patra, S.K. Green synthesis of silver nanoparticles using fresh water green alga Pithophora oedogonia (Mont.) Wittrock and evaluation of their antibacterial activity. Appl. Nanosci. 2015, 5, 703–709. [Google Scholar] [CrossRef]
- Sasikala, A.; Linga Rao, M.; Savithramma, N.; Prasad, T. Synthesis of silver nanoparticles from stem bark of Cochlospermum religiosum (L.) Alston: An important medicinal plant and evaluation of their antimicrobial efficacy. Appl. Nanosci. 2015, 5, 827–835. [Google Scholar] [CrossRef][Green Version]
- Mariadoss, A.V.A.; Ramachandran, V.; Shalini, V.; Agilan, B.; Franklin, J.H.; Sanjay, K.; Alaa, Y.G.; Tawfiq, M.A.-A.; Ernest, D. Green synthesis, characterization and antibacterial activity of silver nanoparticles by Malus domestica and its cytotoxic effect on (MCF-7) cell line. Microb. Pathog. 2019, 135, 103609. [Google Scholar] [CrossRef]
- Ahsan, A.; Farooq, M.A.; Ahsan Bajwa, A.; Parveen, A. Green synthesis of silver nanoparticles using Parthenium hysterophorus: Optimization, characterization and in vitro therapeutic evaluation. Molecules 2020, 25, 3324. [Google Scholar] [CrossRef]
- Macovei, I.; Luca, S.V.; Skalicka-Woźniak, K.; Horhogea, C.E.; Rimbu, C.M.; Sacarescu, L.; Vochita, G.; Gherghel, D.; Ivanescu, B.L.; Panainte, A.D. Silver nanoparticles synthesized from abies alba and pinus sylvestris bark extracts: Characterization, antioxidant, cytotoxic, and antibacterial effects. Antioxidants 2023, 12, 797. [Google Scholar] [CrossRef]
- Halawani, E.M. Rapid biosynthesis method and characterization of silver nanoparticles using Zizyphus spina christi leaf extract and their antibacterial efficacy in therapeutic application. J. Biomater. Nanobiotechnol. 2016, 8, 22–35. [Google Scholar] [CrossRef]
- Logeswari, P.; Silambarasan, S.; Abraham, J. Ecofriendly synthesis of silver nanoparticles from commercially available plant powders and their antibacterial properties. Sci. Iran. 2013, 20, 1049–1054. [Google Scholar]
- Iravani, S.; Zolfaghari, B. Green synthesis of silver nanoparticles using Pinus eldarica bark extract. Biomed Res. Int. 2013, 2013, 639725. [Google Scholar] [CrossRef] [PubMed]
- Madaniyah, L.; Fiddaroini, S.; Hayati, E.K.; Rahman, M.F.; Sabarudin, A. Biosynthesis, characterization, and in-vitro anticancer effect of plant-mediated silver nanoparticles using Acalypha indica Linn: In-silico approach. OpenNano 2025, 21, 100220. [Google Scholar] [CrossRef]
- Alirezalu, A.; Ahmadi, N.; Salehi, P.; Sonboli, A.; Alirezalu, K.; Mousavi Khaneghah, A.; Barba, F.J.; Munekata, P.E.; Lorenzo, J.M. Physicochemical characterization, antioxidant activity, and phenolic compounds of hawthorn (Crataegus spp.) fruits species for potential use in food applications. Foods 2020, 9, 436. [Google Scholar] [CrossRef]
- Arumugam, S.; Ramesh, P. Green synthesis and characterization of zirconium oxide nanoparticles using solanum trilobatum and its photodegradation activity. Sustain. Chem. Clim. Action 2025, 6, 100086. [Google Scholar] [CrossRef]
- Ndikau, M.; Noah, N.M.; Andala, D.M.; Masika, E. Green synthesis and characterization of silver nanoparticles using Citrullus lanatus fruit rind extract. Int. J. Anal. Chem. 2017, 2017, 8108504. [Google Scholar] [CrossRef]
- Kumar, R.; Roopan, S.M.; Prabhakarn, A.; Khanna, V.G.; Chakroborty, S. Agricultural waste Annona squamosa peel extract: Biosynthesis of silver nanoparticles. Spectrochim. Acta A Mol. Biomol. Spectrosc. 2012, 90, 173–176. [Google Scholar] [CrossRef]
- Das, J.; Das, M.P.; Velusamy, P. Sesbania grandiflora leaf extract mediated green synthesis of antibacterial silver nanoparticles against selected human pathogens. Spectrochim. Acta A Mol. Biomol. Spectrosc. 2013, 104, 265–270. [Google Scholar] [CrossRef]
- Vanaja, M.; Paulkumar, K.; Gnanajobitha, G.; Rajeshkumar, S.; Malarkodi, C.; Annadurai, G. Herbal plant synthesis of antibacterial silver nanoparticles by Solanum trilobatum and its characterization. Int. J. Met. 2014, 2014, 692461. [Google Scholar] [CrossRef]
- Sarip, N.A.; Aminudin, N.I.; Danial, W.H. Green synthesis of metal nanoparticles using Garcinia extracts: A review. Environ. Chem. Lett. 2022, 20, 469–493. [Google Scholar] [CrossRef]
- Patel, J.; Kumar, G.S.; Roy, H.; Maddiboyina, B.; Leporatti, S.; Bohara, R.A. From nature to nanomedicine: Bioengineered metallic nanoparticles bridge the gap for medical applications. Discov. Nano 2024, 19, 85. [Google Scholar] [CrossRef]
- Mintiwab, A.; Jeyaramraja, P. Evaluation of phytochemical components, antioxidant and antibacterial activities of silver nanoparticles synthesized using Ricinus communis leaf extracts. Vegetos 2021, 34, 606–618. [Google Scholar] [CrossRef]
- Lim, S.H.; Park, Y. Green synthesis, characterization and catalytic activity of gold nanoparticles prepared using rosmarinic acid. J. Nanosci. Nanotechnol. 2018, 18, 659–667. [Google Scholar] [CrossRef] [PubMed]
- Adebayo-Tayo, B.C.; Akinsete, T.O.; Odeniyi, O.A. Phytochemical composition and comparative evaluation of antimicrobial activities of the juice extract of Citrus aurantifolia and its silver nanoparticles. Niger. J. Pharm. Res. 2016, 12, 59–64. [Google Scholar]
- Dawadi, S.; Katuwal, S.; Gupta, A.; Lamichhane, U.; Thapa, R.; Jaisi, S.; Lamichhane, G.; Bhattarai, D.P.; Parajuli, N. Current research on silver nanoparticles: Synthesis, characterization, and applications. J. Nanomater. 2021, 2021, 6687290. [Google Scholar] [CrossRef]
- Pochapski, D.J.; Carvalho dos Santos, C.; Leite, G.W.; Pulcinelli, S.H.; Santilli, C.V. Zeta potential and colloidal stability predictions for inorganic nanoparticle dispersions: Effects of experimental conditions and electrokinetic models on the interpretation of results. Langmuir 2021, 37, 13379–13389. [Google Scholar] [CrossRef]
- Gengan, R.; Anand, K.; Phulukdaree, A.; Chuturgoon, A. A549 lung cell line activity of biosynthesized silver nanoparticles using Albizia adianthifolia leaf. Colloids Surf. B Biointerfaces 2013, 105, 87–91. [Google Scholar] [CrossRef] [PubMed]
- Varadavenkatesan, T.; Selvaraj, R.; Vinayagam, R. Phyto-synthesis of silver nanoparticles from Mussaenda erythrophylla leaf extract and their application in catalytic degradation of methyl orange dye. J. Mol. Liq. 2016, 221, 1063–1070. [Google Scholar] [CrossRef]
- Padalia, H.; Moteriya, P.; Chanda, S. Green synthesis of silver nanoparticles from marigold flower and its synergistic antimicrobial potential. Arab. J. Chem. 2015, 8, 732–741. [Google Scholar] [CrossRef]
- Salih, A.M.; Al-Qurainy, F.; Khan, S.; Nadeem, M.; Tarroum, M.; Shaikhaldein, H.O. Biogenic silver nanoparticles improve bioactive compounds in medicinal plant Juniperus procera in vitro. Front. Plant Sci. 2022, 13, 962112. [Google Scholar] [CrossRef]
- Kumar, D.; Salvi, A.; Thakur, V.; Kharbanda, S.; Sangwan, S.; Thakur, P.; Thakur, A. Aloe vera assisted green synthesis of silver nanoparticles: Structural characterization, electrochemical behaviour, and antimicrobial efficiency. Discov. Appl. Sci. 2025, 7, 530. [Google Scholar] [CrossRef]
- Modrzejewska-Sikorska, A.; Konował, E. Silver and gold nanoparticles as chemical probes of the presence of heavy metal ions. J. Mol. Liq. 2020, 302, 112559. [Google Scholar] [CrossRef]
- Awaly, S.B.; Osman, N.H.; Farag, H.M.; Yacoub, I.H.; Mahmoud-Aly, M.; Elarabi, N.I.E.; Ahmed, D.S. Evaluation of the morpho-physiological traits and the genetic diversity of durum wheat’s salt tolerance induced by silver nanoparticles. J. Agric. Environ. Int. Dev. 2023, 117, 161–184. [Google Scholar]
- Dubey, R.K.; Shukla, S.; Hussain, Z. Green synthesis of silver nanoparticles; A sustainable approach with diverse applications. Zhongguo Ying Yong Sheng Li Xue Za Zhi 2023, 39, e20230007. [Google Scholar] [CrossRef]
- Anjana, V.; Joseph, M.; Francis, S.; Joseph, A.; Koshy, E.P.; Mathew, B. Microwave assisted green synthesis of silver nanoparticles for optical, catalytic, biological and electrochemical applications. Artif. Cells Nanomed. Biotechnol. 2021, 49, 438–449. [Google Scholar] [CrossRef]
- Fahim, M.; Shahzaib, A.; Nishat, N.; Jahan, A.; Bhat, T.A.; Inam, A. Green synthesis of silver nanoparticles: A comprehensive review of methods, influencing factors, and applications. JCIS Open 2024, 16, 100125. [Google Scholar] [CrossRef]
- Hussain, I.; Singh, N.; Singh, A.; Singh, H.; Singh, S. Green synthesis of nanoparticles and its potential application. Biotechnol. Lett. 2016, 38, 545–560. [Google Scholar] [CrossRef]
- Haridas, E.; Varma, M.; Chandra, G.K. Bioactive silver nanoparticles derived from Carica papaya floral extract and its dual-functioning biomedical application. Sci. Rep. 2025, 15, 1–14. [Google Scholar] [CrossRef]
- Aminnezhad, S.; Zonobian, M.A.; Moradi Douki, M.; Mohammadi, M.R.; Azarakhsh, Y. Curcumin and their derivatives with anti-inflammatory, neuroprotective, anticancer, and antimicrobial activities: A review. Micro Nano Bio Asp. 2023, 2, 25–34. [Google Scholar]
- Stanoiu, A.-M.; Bejenaru, C.; Segneanu, A.-E.; Vlase, G.; Bradu, I.A.; Vlase, T.; Mogoşanu, G.D.; Ciocîlteu, M.V.; Biţă, A.; Kostici, R. Design and Evaluation of a Inonotus obliquus–AgNP–Maltodextrin Delivery System: Antioxidant, Antimicrobial, Acetylcholinesterase Inhibitory and Cytotoxic Potential. Polymers 2025, 17, 2163. [Google Scholar] [CrossRef] [PubMed]
- Yadav, S.; Kumari, P.; Mahto, S.K. Green synthesis of silver nanoparticles using Momordica dioica leaf extract: Characterizing antibacterial, antibiofilm, and catalytic activities. Transit. Met. Chem. 2025, 50, 1151–1168. [Google Scholar] [CrossRef]
- Mohanaparameswari, S.; Balachandramohan, M.; Kumar, K.G.; Revathy, M.; Sasikumar, P.; Rajeevgandhi, C.; Vimalan, M.; Pugazhendhi, S.; Batoo, K.M.; Hussain, S. Green synthesis of silver oxide nanoparticles using Plectranthus amboinicus and Solanum trilobatum extracts as an Eco-friendly approach: Characterization and antibacterial properties. J. Inorg. Organomet. Polym. 2024, 34, 3191–3211. [Google Scholar] [CrossRef]
- Leyva-Porras, C.; Cruz-Alcantar, P.; Espinosa-Solís, V.; Martínez-Guerra, E.; Piñón-Balderrama, C.I.; Compean Martínez, I.; Saavedra-Leos, M.Z. Application of differential scanning calorimetry (DSC) and modulated differential scanning calorimetry (MDSC) in food and drug industries. Polymers 2019, 12, 5. [Google Scholar] [CrossRef] [PubMed]
- Agnihotri, S.; Mukherji, S.; Mukherji, S. Size-controlled silver nanoparticles synthesized over the range 5–100 nm using the same protocol and their antibacterial efficacy. Rsc. Adv. 2014, 4, 3974–3983. [Google Scholar] [CrossRef]
- Karuna, D.; Dey, P.; Das, S.; Kundu, A.; Bhakta, T. In vitro antioxidant activities of root extract of Asparagus racemosus Linn. J. Tradit. Complement. Med. 2018, 8, 60–65. [Google Scholar] [CrossRef]
- Rajeshkumar, S.; Bharath, L. Mechanism of plant-mediated synthesis of silver nanoparticles–a review on biomolecules involved, characterisation and antibacterial activity. Chem. Biol. Interact. 2017, 273, 219–227. [Google Scholar] [CrossRef] [PubMed]
- El Badawy, A.M.; Silva, R.G.; Morris, B.; Scheckel, K.G.; Suidan, M.T.; Tolaymat, T.M. Surface charge-dependent toxicity of silver nanoparticles. Environ. Sci. Technol. 2011, 45, 283–287. [Google Scholar] [CrossRef]
- Shayo, G.M.; Elimbinzi, E.; Shao, G.N. Preparation methods, applications, toxicity and mechanisms of silver nanoparticles as bactericidal agent and superiority of green synthesis method. Heliyon 2024, 10, e36539. [Google Scholar] [CrossRef] [PubMed]
- Tippayawat, P.; Phromviyo, N.; Boueroy, P.; Chompoosor, A. Green synthesis of silver nanoparticles in aloe vera plant extract prepared by a hydrothermal method and their synergistic antibacterial activity. PeerJ 2016, 4, e2589. [Google Scholar] [CrossRef] [PubMed]
- Vélez, E.; Campillo, G.; Morales, G.; Hincapié, C.; Osorio, J.; Arnache, O. Silver nanoparticles obtained by aqueous or ethanolic aloe Vera extracts: An assessment of the antibacterial activity and mercury removal capability. J. Nanomater. 2018, 2018, 7215210. [Google Scholar] [CrossRef]
- Haripriya, S.; Ajitha, P. Antimicrobial efficacy of silver nanoparticles of Aloe vera. J. Adv. Pharm. Educ. Res. 2017, 7, 163–166. [Google Scholar] [CrossRef]
- Urnukhsaikhan, E.; Bold, B.-E.; Gunbileg, A.; Sukhbaatar, N.; Mishig-Ochir, T. Antibacterial activity and characteristics of silver nanoparticles biosynthesized from Carduus crispus. Sci. Rep. 2021, 11, 21047. [Google Scholar] [CrossRef]
- Ojha, S.; Sett, A.; Bora, U. Green synthesis of silver nanoparticles by Ricinus communis var. carmencita leaf extract and its antibacterial study. Adv. Nat. Sci. Nanosci. Nanotechnol. 2017, 8, 035009. [Google Scholar] [CrossRef]
- Nemudzivhadi, V.; Masoko, P. In vitro assessment of cytotoxicity, antioxidant, and anti-inflammatory activities of Ricinus communis (Euphorbiaceae) leaf extracts. Evid. Based Complement. Altern. Med. 2014, 2014, 625961. [Google Scholar] [CrossRef]
- Valderramas, A.C.; Moura, S.H.P.; Couto, M.; Pasetto, S.; Chierice, G.O.; Guimarães, S.A.C.; Zurron, A.C.B.d.P. Antiinflammatory activity of Ricinus communis derived polymer. Braz. J. Oral Sci. 2008, 7, 1666–1672. [Google Scholar]
- Varghese, R.M.; Kumar, A.; Shanmugam, R. Comparative anti-inflammatory activity of silver and zinc oxide nanoparticles synthesized using Ocimum tenuiflorum and Ocimum gratissimum herbal formulations. Cureus 2024, 16, e52995. [Google Scholar] [CrossRef]
- Khashan, A.A.; Dawood, Y.; Khalaf, Y.H. Green chemistry and anti-inflammatory activity of silver nanoparticles using an aqueous curcumin extract. Results Chem. 2023, 5, 100913. [Google Scholar] [CrossRef]
- Dharmadeva, S.; Galgamuwa, L.S.; Prasadinie, C.; Kumarasinghe, N. In vitro anti-inflammatory activity of Ficus racemosa L. bark using albumin denaturation method. AYU 2018, 39, 239–242. [Google Scholar]
- Matkowski, A.; Tasarz, P.; Szypuła, E. Antioxidant activity of herb extracts from five medicinal plants from Lamiaceae, subfamily Lamioideae. J. Med. Plants Res. 2008, 2, 321–330. [Google Scholar]
- Silva, F.; Veiga, F.; Cardoso, C.; Dias, F.; Cerqueira, F.; Medeiros, R.; Paiva-Santos, A.C. A rapid and simplified DPPH assay for analysis of antioxidant interactions in binary combinations. Microchem. J. 2024, 202, 110801. [Google Scholar] [CrossRef]
- Sohal, J.K.; Saraf, A.; Shukla, K.; Shrivastava, M. Determination of antioxidant potential of biochemically synthesized silver nanoparticles using Aloe vera gel extract. Plant Sci. Today 2019, 6, 208–217. [Google Scholar] [CrossRef]
- More, G.K.; Makola, R.T. In-vitro analysis of free radical scavenging activities and suppression of LPS-induced ROS production in macrophage cells by Solanum sisymbriifolium extracts. Sci. Rep. 2020, 10, 6493. [Google Scholar] [CrossRef] [PubMed]
- Rana, M.S.; Rayhan, N.M.A.; Emon, M.S.H.; Islam, M.T.; Rathry, K.; Hasan, M.M.; Mansur, M.M.I.; Srijon, B.C.; Islam, M.S.; Ray, A. Antioxidant activity of Schiff base ligands using the DPPH scavenging assay: An updated review. RSC Adv. 2024, 14, 33094–33123. [Google Scholar] [CrossRef]
- He, W.; Zhou, Y.-T.; Wamer, W.G.; Boudreau, M.D.; Yin, J.-J. Mechanisms of the pH dependent generation of hydroxyl radicals and oxygen induced by Ag nanoparticles. Biomaterials 2012, 33, 7547–7555. [Google Scholar] [CrossRef]
- Mata, R.; Nakkala, J.R.; Sadras, S.R. Biogenic silver nanoparticles from Abutilon indicum: Their antioxidant, antibacterial and cytotoxic effects in vitro. Colloids Surf. B Biointerfaces 2015, 128, 276–286. [Google Scholar] [CrossRef]
- Irfan, A.; Jardan, Y.A.B.; Rubab, L.; Hameed, H.; Zahoor, A.F.; Supuran, C.T. Bacterial tyrosinases and their inhibitors. Enzymes 2024, 56, 231–260. [Google Scholar]
- Mukherjee, P.K.; Biswas, R.; Sharma, A.; Banerjee, S.; Biswas, S.; Katiyar, C. Validation of medicinal herbs for anti-tyrosinase potential. J. Herb. Med. 2018, 14, 1–16. [Google Scholar] [CrossRef]
- Özer, Ö.; Mutlu, B.; Kıvçak, B. Antityrosinase activity of some plant extracts and formulations containing ellagic acid. Pharm. Biol. 2007, 45, 519–524. [Google Scholar] [CrossRef]
- Manickam, V.; Mani, G.; Muthuvel, R.; Pushparaj, H.; Jayabalan, J.; Pandit, S.S.; Elumalai, S.; Kaliappan, K.; Tae, J.H. Green fabrication of silver nanoparticles and it’s in vitro anti-bacterial, anti-biofilm, free radical scavenging and mushroom tyrosinase efficacy evaluation. Inorg. Chem. Commun. 2024, 162, 112199. [Google Scholar] [CrossRef]
- Verma, S.K.; Jha, E.; Sahoo, B.; Panda, P.K.; Thirumurugan, A.; Parashar, S.; Suar, M. Mechanistic insight into the rapid one-step facile biofabrication of antibacterial silver nanoparticles from bacterial release and their biogenicity and concentration-dependent in vitro cytotoxicity to colon cells. RSC Adv. 2017, 7, 40034–40045. [Google Scholar] [CrossRef]
- Akter, M.; Sikder, M.T.; Rahman, M.M.; Ullah, A.A.; Hossain, K.F.B.; Banik, S.; Hosokawa, T.; Saito, T.; Kurasaki, M. A systematic review on silver nanoparticles-induced cytotoxicity: Physicochemical properties and perspectives. J. Adv. Res. 2018, 9, 1–16. [Google Scholar] [CrossRef] [PubMed]
- Sati, A.; Mali, S.N.; Ranade, T.N.; Yadav, S.; Pratap, A. Silver Nanoparticles (AgNPs) as a Double-Edged Sword: Synthesis, Factors Affecting, Mechanisms of Toxicity and Anticancer Potentials—An Updated Review till March 2025. Biol. Trace Elem. Res. 2025, 1–52, in press. [Google Scholar] [CrossRef] [PubMed]
- Garrido, C.; Galluzzi, L.; Brunet, M.; Puig, P.; Didelot, C.; Kroemer, G. Mechanisms of cytochrome c release from mitochondria. Cell Death Differ. 2006, 13, 1423–1433. [Google Scholar] [CrossRef]
- Abbas, M.; Ali, A.; Arshad, M.; Atta, A.; Mehmood, Z.; Tahir, I.M.; Iqbal, M. Mutagenicity, cytotoxic and antioxidant activities of Ricinus communis different parts. Chem. Cent. J. 2018, 12, 3. [Google Scholar] [CrossRef]
- Erhabor, J.O.; Idu, M. In vitro antibacterial, antioxidant, cytogenotoxic and nutritional value of Aloe barbadensis Mill.(Asphodelaceae). J. Microbiol. Biotechnol. Food Sci. 2020, 10, 10–21. [Google Scholar] [CrossRef]
- Pawar, A.A.; Sahoo, J.; Verma, A.; Alswieleh, A.M.; Lodh, A.; Raut, R.; Lakkakula, J.; Jeon, B.-H.; Islam, M.R. Azadirachta indica-Derived Silver Nanoparticle Synthesis and Its Antimicrobial Applications. J. Nanomater. 2022, 2022, 4251229. [Google Scholar] [CrossRef]
- Khac, K.T.; Phu, H.H.; Thi, H.T.; Thuy, V.D.; Do Thi, H. Biosynthesis of silver nanoparticles using tea leaf extract (Camellia sinensis) for photocatalyst and antibacterial effect. Heliyon 2023, 9, e20707. [Google Scholar] [CrossRef] [PubMed]
- Mohammed, A.A.; Mohamed, A.; El-Naggar, N.E.-A.; Mahrous, H.; Nasr, G.M.; Abdella, A.; Ahmed, R.H.; Irmak, S.; Elsayed, M.S.; Selim, S. Antioxidant and antibacterial activities of silver nanoparticles biosynthesized by Moringa Oleifera through response surface methodology. J. Nanomater. 2022, 2022, 9984308. [Google Scholar] [CrossRef]
- Gautam, D.; Dolma, K.G.; Khandelwal, B.; Gupta, M.; Singh, M.; Mahboob, T.; Teotia, A.; Thota, P.; Bhattacharya, J.; Goyal, R. Green synthesis of silver nanoparticles using Ocimum sanctum Linn. and its antibacterial activity against multidrug resistant Acinetobacter baumannii. PeerJ 2023, 11, e15590. [Google Scholar] [CrossRef]

| Phytochemicals | Aqueous Extract | Methanolic Extract | ||
|---|---|---|---|---|
| Ricinus communis | Aloe barbadensis | Ricinus communis | Aloe barbadensis | |
| Alkaloids | − | + | + | + |
| Steroids | − | − | + | + |
| Flavonoids | + | + | + | + |
| Terpenoids | + | − | + | + |
| Glycosides | + | − | − | − |
| Phenols | − | + | + | + |
| Tannins | + | + | + | − |
| Saponins | + | − | + | + |
| Reducing sugars | + | + | + | + |
| Microorganisms | RcSNPs | AbSNPs | Standard | Control | |||||
|---|---|---|---|---|---|---|---|---|---|
| 50 μL | 100 μL | 50 μL | 100 μL | Gentamycin | Fluconazole | Rc Extract | Ab Extract | ||
| Bacteria | S. aureus | 18.32 ± 0.3 | 20.2 ± 0.2 | 17.2 ± 0.1 | 20.3 ± 0.1 | 25.2 ± 0.3 | - | 12.3 ± 0.4 | 10.4 ± 0.5 |
| S. typhi | 18.1 ± 0.7 | 19.3 ± 0.5 | 14.5 ± 0.1 | 18.6 ± 0.1 | 27.8 ± 0.1 | - | 14.6 ± 0.4 | 8.6 ± 0.6 | |
| E. coli | 17.6 ± 0.9 | 18.4 ± 0.7 | 16.1 ± 0.05 | 17.3 ± 0.05 | 23.4 ± 0.1 | - | 11.2 ± 0.7 | 11.7 ± 0.3 | |
| Fungi | C. albicans | 20.1 ± 0.7 | 22.3 ± 0.8 | 17.25 ± 0.2 | 20.5 ± 0.1 | - | 22.8 ± 0.7 | 10.7 ± 0.9 | 13.6 ± 0.2 |
| A. niger | 19.4 ± 0.7 | 21.4 ± 0.7 | 22.5 ± 0.3 | 24.3 ± 0.4 | - | 23.21 ± 0.7 | 9.8 ± 0.2 | 17.1 ± 0.8 | |
| Testing Material | Tyrosinase Inhibition (%) |
|---|---|
| RcSNPs | 97.98 ± 1.5 |
| AbSNPs | 98.43 ± 1.5 |
| Ascorbic acid | 99.23± 0.1 |
| Source (Plant Extract) | Particle Size (nm) | Shape | Synthesis Features | Antimicrobial Activity (Zone of Inhibition, mm) | Cytotoxic/Other Bioactivity | Reference |
|---|---|---|---|---|---|---|
| Azadirachta indica (Neem) | 25–45 | Spherical | Moderate stability; slow reduction (4 h) | E. coli—17 ± 0.5 mm | Moderate anticancer (IC50 > 100 µg/mL) | [167] |
| Camellia sinensis (Green tea) | 30–60 | Quasi-spherical | Good dispersion; requires heating | S. aureus—18 ± 0.7 mm | Low cytotoxicity (IC50 > 150 µg/mL) | [168] |
| Moringa oleifera | 20–40 | Spherical | High yield; moderate stability | E. coli—19 ± 0.4 mm | Limited antiproliferative effect | [169] |
| Ocimum sanctum (Tulsi) | 18–30 | Irregular | Requires alkaline pH > 9 | A. baumannii—15 ± 0.8 mm | Moderate anticancer (IC50 > 125 µg/mL | [170] |
| Ricinus communis (present study) | 16–22 | Uniform spherical | Rapid synthesis (≤30 min); high stability (>3 mo) | S. aureus—20.2 ± 0.9 mm; C. albicans—22.3 ± 0.8 mm | Strong cytotoxicity (B16F10 IC50 ≈ 52 µg/mL) | This study |
| Aloe barbadensis (present study) | 18–24 | Spherical | Good colloidal stability; reproducible synthesis | A. niger—21.8 ± 0.4 mm; E. coli—17.3 ± 0.05 mm | Significant cytotoxicity (HepG2 IC50 ≈ 60 µg/mL) | This study |
Disclaimer/Publisher’s Note: The statements, opinions and data contained in all publications are solely those of the individual author(s) and contributor(s) and not of MDPI and/or the editor(s). MDPI and/or the editor(s) disclaim responsibility for any injury to people or property resulting from any ideas, methods, instructions or products referred to in the content. |
© 2025 by the authors. Licensee MDPI, Basel, Switzerland. This article is an open access article distributed under the terms and conditions of the Creative Commons Attribution (CC BY) license (https://creativecommons.org/licenses/by/4.0/).
Share and Cite
Ahsan, A.; Gao, G.F.; Tian, W.-X. Phytogenic Silver Nanoparticles Derived from Ricinus communis and Aloe barbadensis: Synthesis, Characterization, and Evaluation of Biomedical Potential. Bioengineering 2025, 12, 1273. https://doi.org/10.3390/bioengineering12111273
Ahsan A, Gao GF, Tian W-X. Phytogenic Silver Nanoparticles Derived from Ricinus communis and Aloe barbadensis: Synthesis, Characterization, and Evaluation of Biomedical Potential. Bioengineering. 2025; 12(11):1273. https://doi.org/10.3390/bioengineering12111273
Chicago/Turabian StyleAhsan, Anam, George F. Gao, and Wen-Xia Tian. 2025. "Phytogenic Silver Nanoparticles Derived from Ricinus communis and Aloe barbadensis: Synthesis, Characterization, and Evaluation of Biomedical Potential" Bioengineering 12, no. 11: 1273. https://doi.org/10.3390/bioengineering12111273
APA StyleAhsan, A., Gao, G. F., & Tian, W.-X. (2025). Phytogenic Silver Nanoparticles Derived from Ricinus communis and Aloe barbadensis: Synthesis, Characterization, and Evaluation of Biomedical Potential. Bioengineering, 12(11), 1273. https://doi.org/10.3390/bioengineering12111273

